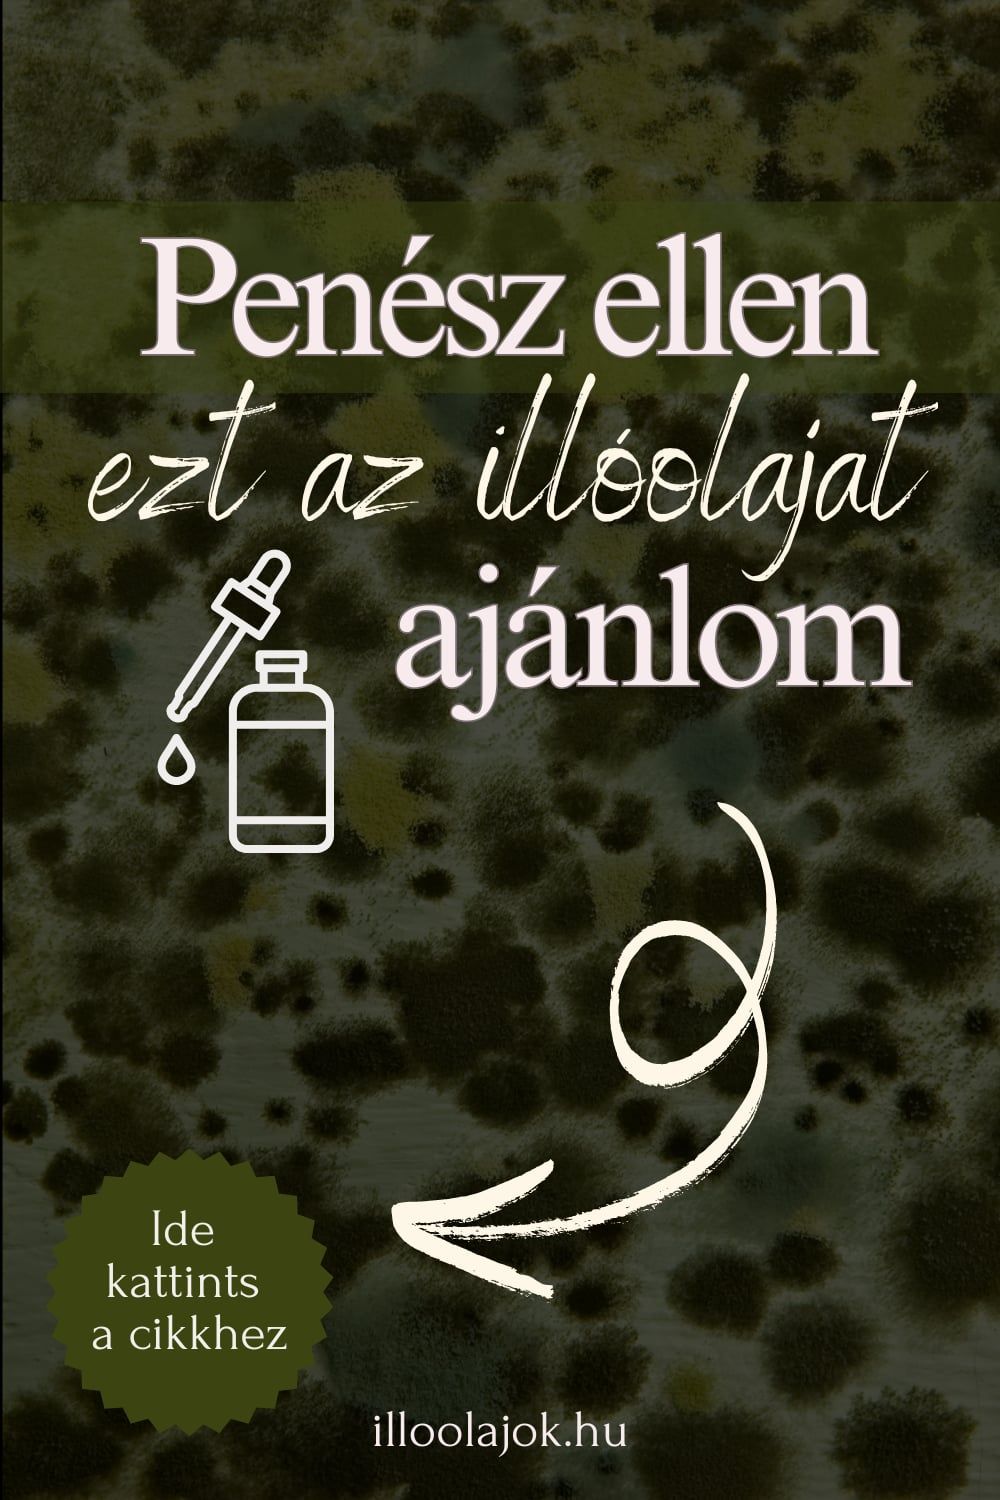

Légfertőtlenítés

Citrom, Air, Onguard, mandarin, szibériai fenyő, eukaliptusz, vadnarancs...
Az illóolajok használata kiváló módja a természetes, kellemes illatokkal teli környezet kialakításának. Az illóolajok segítségével nemcsak a levegőt fertőtleníthetjük, hanem a hangulatot is javíthatjuk, és stresszcsökkentő hatásuk is lehet.
Most megosztok néhány tippet arról, hogyan lehet illóolajokat használni a levegő fertőtlenítésére.
1. Párásítók és diffúzorok használata:
Az egyik legegyszerűbb módja az illóolajok levegőbe juttatásának a párásítók vagy diffúzorok használata. Ezek az eszközök permetezik a levegőbe az illóolajokat, így könnyedén szétszórják a szobában. Az olajok hozzáadásával nemcsak a levegőt fertőtlenítjük, hanem kellemes illatot is teremtünk.
2. Illóolajok direkt alkalmazása:
Az illóolajokat közvetlenül is használhatjuk. Egy tál forró vízben néhány csepp illóolajat csepegtethetünk, majd belélegezhetjük a gőzt. Például eukaliptusz illóolajat használhatunk, hogy segítsünk a légzőszervek tisztításában. Az aromalámpába is csepegtethetünk néhány csepp illóolajat.
3. Illóolajos spray-készítés:
Készíthetünk saját illóolajos spray-t, amelyet használhatunk a levegő fertőtlenítésére. Ehhez vegyünk egy spray-palackot, és töltsük fel vízzel. Majd adjunk hozzá néhány csepp illóolajat (például levendula vagy teafa olajat), és alaposan rázzuk össze. Ezzel a spray-vel könnyedén permetezhetjük a szobában, vagy akár a textíliákra is.
4. Illóolajos levegőtisztítók:
Néhány levegőtisztító készülék illóolajokat is használ. Ezek az eszközök a levegő tisztítása mellett aromaterápiás előnyöket is nyújtanak.
Fontos megjegyezni, hogy az illóolajokat mindig óvatosan kell használni. Néhány illóolaj irritálhatja a bőrt, vagy allergiás reakciót válthat ki, ezért mindig kezdd cseppenként, és figyeld a reakciót. Továbbá, ha háziállatok vannak a lakásban, ellenőrizd, hogy az illóolajok biztonságosak-e számukra, mivel néhány illóolaj mérgező lehet a kisállatok számára.
Az illóolajok használata kellemes és természetes módja a levegő fertőtlenítésének, és a megfelelő illóolaj kiválasztásával különböző egészségügyi problémákra is pozitív hatással lehetnek.
Saját illóolajos termékeim:
? Aromaterápiás TERVEZŐ – hogy tudatosan és örömmel használd az illóolajokat minden nap!
Nézd meg itt >>
? Illóolajos KÁRTYÁK – a testi-lelki megújulásodhoz, nyomtatható kártyák formájában.
Töltsd le innen >>
? AromaGrill – 100 illóolajos étel- és italrecept nyári grilezéshez
Nézz bele itt >>
? Aroma NYAKLÁNCOK – viseld nyakadban az illatod! Vagy ajándékozd meg vele illóolaj-rajongó ismerőseidet!
Webshop >>
Betti,
Kiss Bernadett, az illoolajok.hu weboldal létrehozója
További cikkek

Tisztítás citromolajjal – Hogyan tartsd fényesen a rozsdamentes acélt természetesen

DIY öblítő illóolajokból
Penészes a lakásunk

Természetes illatú öblítővíz

Felületfertőtlenítés falfestéskor

Padlótisztítás illóolajokkal

Szőnyegtisztítás illóolajokkal

Tudod, hol van a legtöbb baktérium a lakásodban?

Levegőfertőtlenítés 3 hetes baba mellett

Illóolajok az öblítővízben
Blog
- Aromaékszerek
- Illóolajos DIY
- Ajándékötletek
- Készíts parfümöt!
- Várandósság, szülés
- Érzékiség, szexualitás
- Érdekességek
- Keverékek párologtatóba
- Sütés, főzés illóolajokkal
- Diffúzorok használata
- Illóolajok hatásai
- Szépségápolás
- Háztartás
- Felnőttek
- Gyerekeknek
- Hogyan használd?
- BEMER terápia
- doTERRA vásárlás
- Aromaterápiás tervezők és naplók
- Illóolajos kártyák
- AromArt minták pólón, bögrén
